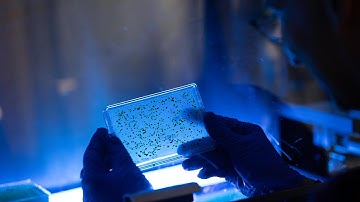
Martin Jonikas: 2020 Vilcek Prize for Creative Promise in Biomedical Science

⬇ DOWNLOAD NOW
Jika muncul iklan pop-up, tutup lalu klik tombol kembali
Download lagu Lightning Talk: How We Validate User Initiated Config Changes in Promet... G. Michalec & I. Skorjanc secara gratis hanya untuk keperluan promosi. Dukung artis favorit kamu dengan membeli musik original di iTunes atau platform resmi lainnya.
 Bliksempraat | Jakub Červinka | DevFest.cz 2025
Bliksempraat | Jakub Červinka | DevFest.cz 2025 RightsCon 2021 Lightning Talk: Validating & Enforcing Transparency Reports
RightsCon 2021 Lightning Talk: Validating & Enforcing Transparency Reports Het "waarom" is belangrijker dan het "wat"
Het "waarom" is belangrijker dan het "wat" Martin Jonikas: 2020 Vilcek Prize for Creative Promise in Biomedical Science
Martin Jonikas: 2020 Vilcek Prize for Creative Promise in Biomedical Science Lightning talks, showing how we’re tackling grand challenges in water security & digital innovation.
Lightning talks, showing how we’re tackling grand challenges in water security & digital innovation. Validation
Validation Lightning talks: Aligning models with human intent
Lightning talks: Aligning models with human intent rta_01_vulnerability.mp4
rta_01_vulnerability.mp4